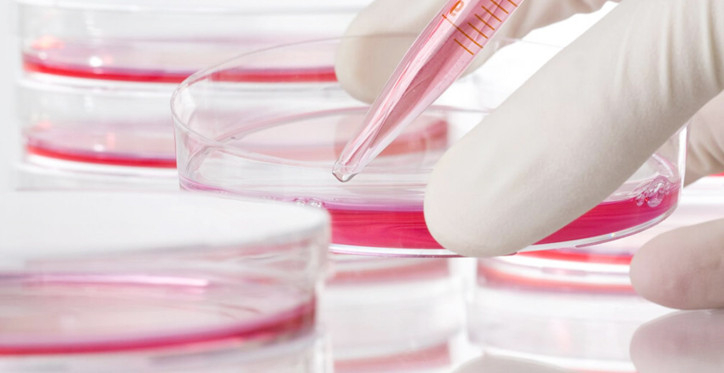

A témában számos sajtóorgánum azt állítja, hogy a meddőségkezelés területén nincs más alternatíva, vagy nem bizonyított, hogy hatásos volna.
Az állítást cáfolandó szeretnénk mindenki figyelmébe ajánlani a kérdésben 2017-ben kiadott könyvünket, illetve azokat az interjúkat, amelyeket olyan családokkal készítettünk, amelyeknél a Katolikus Egyház tanításával összhangban lévő NaPro Technológia nyomán volt sikeres a meddőségkezelés és a gyermekfogantatás. A Záhonyi családdal készült interjú ITT, a Schattmann családdal készült interjú ITT olvasható.
Az Új Ember Kiadványok sorozatában megjelent Gyermekáldás természetesen című kötetünket Veres András győri püspök, a Magyar Katolikus Püspöki Konferencia (MKPK) elnöke mutatta be 2017. november 30-án Budapesten. Az interjúkötetben szakemberek és házaspárok beszélnek a NaPro Technológiáról.
Köztudott dolog, hogy előfordul, meddőnek hitt házaspár például örökbefogadás után fogan természetesen gyereket. Tudjuk, hogy az örökbefogadás nem feltétlenül minden házaspár számára járható út, mégis, a fent említett jelenség is jól rávilágít arra, hogy a gyermektelenség biológiai és lelki eredetű okait most, a 21. században sem ismerjük és gyógyítjuk még teljeskörűen – annak ellenére, hogy az egészségügy számos területén egyre elterjedtebb az oki orvoslás gyakorlata. Manapság
még mindig kevés figyelmet és egészségügyi támogatást fordítanak a meddőségi okok feltárására és gyógyítására. Jellemzően az érintett házaspároknak rögtön olyan eljárást javasolnak, amely nem gyógyítja a meddőséget, hanem megkerüli azt.
Ezek az asszisztált reprodukciós eljárások számos erkölcsi aggályt keltenek és egészségügyi problémát okoznak.
Az Egyház nem öncélúan, érzéketlenségből jelenti ki azt, amit tanít, hanem kitartóan és következetesen hirdeti, hogy az élet ura az Isten – miközben a gyógyítás természetesen továbbra is fontos és szükséges szolgálat az emberiség számára. Azonban
nem gondolhatjuk azt, hogy az embernek jogában állna dönteni az élet kezdetéről és az élet végéről.
A sajtóhírekben sajnos olyan manipulatív váddal is találkozhattunk, hogy az Egyház megveti azokat a gyerekeket, akik lombikbébiprogram során fogantak. Szó sincs róla! Hiszen
a Katolikus Egyház tanítása szerint az életet minden körülmények között tisztelni, becsülni és védeni kell.
Minden ember élete érték – függetlenül attól, hogy várták-e, vagy sem, szeretetteljes, vagy esetleg erőszakos körülmények közt fogant-e meg. Védelem illeti az embert, minden embert.
Veres András püspök annak fontosságát is hangsúlyozta, hogy „minden embernek joga van ahhoz, hogy szülei természetes szeretetkapcsolatából foganjon”.
Ennek testi és lélektani szempontból is fontos következménye van a gyermek és a szülők számára is – számos pszichológiai tanulmány szól erről.
A könyvbemutatón elhangzott előadása végén a Magyar Katolikus Püspöki Konferencia elnöke a kiadvány érdemeit kiemelve rámutatott: „Bízom benne, hogy a gyermektelenség keresztjét hordozó házaspárok közül egyre többen fordulnak majd ahhoz a technológiához, mely nem kikerüli a problémát, hanem meg szeretné azt gyógyítani.”
*
2018 óta tart a Katolikus Szeretetszolgálat „Természetes gyermekáldás” projektje az Emberi Erőforrások Minisztériumának támogatásával. Ennek kifejezett célja, hogy a magyar társadalom, a szakemberek és a laikusok egyaránt megismerhessenek olyan módszereket és orvosi protokollokat, amelyek a gyermekáldás elmaradása okainak feltárásában és gyógyításában nyújthatnak segítséget.
A projekt olyan módszereket népszerűsít, melyek a gyógyítást és a gyermekek természetes megfoganását teszik lehetővé.
Ezek orvosszakmailag és a Katolikus Egyház tanítása szerint is teljes mértékben elfogadhatók. Sem az orvosoknak, sem a pácienseknek nem okoznak egészségügyi vagy lelkiismereti problémát.
A projekt keretein belül magyar orvosoknak (nőgyógyászok, endokrinológusok, összesen 40 fő) volt lehetőségük NaPro Technológia- és/vagy FEMM Health-képzéseken részt venni.
A budapesti képzésről portálunk is beszámolt.
Mind a NaPro Technológia, mind a FEMM Health a helyreállító, oki orvoslás részét képezi. Azaz gyermekáldás elmaradása esetén annak okát keresi, és az egészséget állítja vissza, hogy a gyermekáldásra természetesen kerülhessen sor. Vallja, hogy a meddőség tünet, nem pedig diagnózis; az okot kell megtalálni, akár női, akár férfi oldalon van az. Így a kivizsgálás nagyon alapos, egyéni, nők esetében a női ciklussal összhangban történik. Mindez azt is jelenti, hogy hosszadalmasabb folyamat. A meddőséget kiváltó ok/okok feltárása akár fél évet is igénybe vehet, azt követően pedig a gyógyításnak köszönhetően a házaspár egészségesen és természetesen vállalhat gyermeket, vagy akár több gyermeket is.
A helyreállító orvoslás diagnosztikai eszközei a modern orvostudomány által biztosított hormonvizsgálatok, a különféle sebészeti eszközök, laparoszkóp, ultrahang; elsődleges diagnosztikai eszköze pedig a nők ciklustáblázata.
A saját ciklus megfigyelése és jegyzése akár 2-3 hónap alatt is elsajátítható a szakképzett cikluskövetés-oktatónál. A Természetes gyermekáldás projekt részeként eddig harminc cikluskövetés-oktató végzett, és elkészült egy honlap (www.cikluskovetes.hu) is, amelyen az érdeklődő nők és házaspárok olvashatnak a cikluskövetésről, felvehetik személyesen is a kapcsolatot egy-egy oktatóval.
Ha egy házaspár szembesül azzal, hogy a gyermekáldás várat magára, és ezért orvoshoz fordul, érdemes tudnia, hogy ha tud mutatni legalább 2-3 ciklusnyi pontosan vezetett megfigyelést, a helyreállító módszereket alkalmazó orvos jelentősen szűkíteni tudja a lehetséges diagnózisok körét.
A cikluskövetés elsajátításához felkereshető oktatók honlapja: www.cikluskovetes.hu.
A FEMM Health-képzést végzett orvosok listája megtalálható az amerikai FEMM központ honlapján. A NaPro Technológiát alkalmazó orvosok listáját is tartalmazó honlap IDE klikkelve érhető el.
Fotó: Pixabay
Magyar Kurír
(ki)
Kapcsolódó fotógaléria